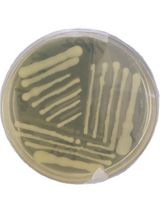
Simple and Fail-safe Method to Transform Miniprep <em>Escherichia coli</em> Strain K12 Plasmid DNA Into Viable <em>Agrobacterium tumefaciens</em> EHA105 Cells for Plant Genetic Transformation

Published: Vol 15, Iss 6, Mar 20, 2025 DOI: 10.21769/BioProtoc.5241 Views: 1918
Reviewed by: Anonymous reviewer(s)

Protocol Collections
Comprehensive collections of detailed, peer-reviewed protocols focusing on specific topics
Related protocols

A Guideline for Assessment and Characterization of Bacterial Biofilm Formation in the Presence of Inhibitory Compounds
Bassam A. Elgamoudi and Victoria Korolik
Nov 5, 2023 2791 Views
Simple and Fail-safe Method to Transform Miniprep Escherichia coli Strain K12 Plasmid DNA Into Viable Agrobacterium tumefaciens EHA105 Cells for Plant Genetic Transformation
Beenzu Siamalube [...] Steven Runo
Jan 5, 2025 2100 Views

In Silico Prediction and In Vitro Validation of Bacterial Interactions in the Plant Rhizosphere Using a Synthetic Bacterial Community
Arijit Mukherjee [...] Sanjay Swarup
Nov 5, 2025 1357 Views
Abstract
Plant growth–promoting rhizobacteria (PGPR) can be used as biofertilizers to enhance crop growth for better yield and soil fertility restoration. PGPR possesses certain traits such as nutrient solubilization, phytohormone production, and production of key enzymes for improved crop growth. These traits are also important for inhibiting the growth of plant root pathogens, improving root development, and conferring stress tolerance. However, the mere presence of PGPR traits in isolated bacteria may not directly reflect an improvement in plant growth, warranting researchers to evaluate phenotypic and physiological changes upon inoculation. The current manuscript provides a detailed step-by-step procedure for inoculating the PGPR Staphylococcus sciuri into seeds and seedlings of rice and tomato plants for visualizing the enhancement of root and shoot growth. The surface-sterilized seeds of rice and tomato plants are inoculated overnight with an actively grown log-phase culture of S. sciuri, and differences in growth and biomass of seedlings that emerged from the inoculated and uninoculated seeds are analyzed 10 days after germination. Plants grown in pots with sterile soil are also treated with PGPR S. sciuri by soil drenching. A remarkable increase in root and shoot growth is observed in inoculated plants. We suggest that treating seeds with bacteria and enriching the soil with bacterial inoculum provides an adequate load of PGPR that facilitates growth improvement. This method can be a reliable choice for screening and evaluating plant growth promotion by either isolated bacteria or bacterial consortia with plant-beneficial traits.
Key features
• Inoculation of seeds and seedlings with an actively grown log-phase culture of S. sciuri can induce root and shoot growth in rice and tomato plants.
• The improvement of root and shoot growth due to inoculation with S. sciuri can be evaluated under laboratory conditions.
• The method can be used to screen bacteria with plant growth promotion ability under laboratory conditions.
• The method is robust and can be used for evaluating the plant growth–promoting ability of many bacteria and the inoculation of multiple plant species.
Keywords: Plant growth–promoting rhizobacteriaGraphical overview
Graphical overview of inoculation of seeds and seedlings of rice plants with plant growth–promoting rhizobacteria (PGPR) for increased root and shoot growth
Background
Among the vast majority of microorganisms found in soil, plant growth–promoting rhizobacteria (PGPR) colonize the rhizosphere or grow inside roots and have the ability to improve plant growth under normal and stress conditions [1–3]. PGPR offer various benefits to host plants, including increased nutrient availability, modulation of phytohormone production, mitigation of biotic and abiotic stresses, protection from pathogens, and improved plant growth [3,4]. Bacteria with plant growth–promoting traits can be isolated from different soil types and ecosystems, but evaluating this ability in isolated bacteria requires the use of a reliable and stable method for inoculation. As per the literature, PGPR inoculation is performed on seeds by coating, treating the soil with bacteria, soil drenching, or application of bacteria via foliar spray [5,6]. All these treatments are proven to be effective in certain crops with specific advantages and disadvantages [7]. Often, the bacterial load and the survival of the bacteria in the soil are questioned [8]. Therefore, a reliable and robust inoculation protocol is required that can be used for bacterial inoculation on multiple crop species and for screening the plant growth–promoting ability of multiple bacteria or consortia [7,9]. A successful bacterial inoculation depends on various factors like the inoculation technique, density of inoculum given to the host crop, bacteria effectiveness in root colonization, soil humidity, pH, temperature, developmental stage of the plant being inoculated, and root exudate status [10,11]. In the current protocol, a combination of seed inoculation and soil drenching is described for assessing increased root and shoot growth of Oryza sativa and Lycopersicon esculentum plants.
Materials and reagents
Biological material
1. Bacterial strain Staphylococcus sciuri ET101, halotolerant PGPR isolated from the rhizosphere of Salicornia species
2. Oryza sativa (Aiswarya cultivar), purchased from Regional Agricultural Research Station, Pattambi, Kerala, India
3. Lycopersicon esculentum (PKM seeds), purchased from Sri Venkateswara Agro Store, Tiruchirappalli, Tamil Nadu, India
Reagents
1. LB agar (SRL, catalog number: LM018)
2. LB broth (Himedia, catalog number: M1245)
3. Absolute ethanol (Analytic CS Reagent, catalog number: 1170)
4. Sodium hypochlorite (Nice, catalog number: S2195)
5. KCl (Merck, catalog number: 1.93238.0521)
6. NaCl (Merck, catalog number: 1.93606.0521)
7. Na2HPO4 (Merck, catalog number: 1.93209.0521)
8. KH2PO4 (Merck, catalog number: 1.93205.0521)
9. NaOH (SRL, catalog number: 68151)
10. HCl (Finar, catalog number: 70770L8M50)
Solutions
1. 10× phosphate-buffered saline (PBS) (see Recipes)
Recipes
1. 10× phosphate-buffered saline (PBS)
| Reagents | Final concentration |
|---|---|
| NaCl | 1.37 M |
| KCl | 27 mM |
| Na2HPO4 | 100 mM |
| KH2PO4 | 18 M |
| Sterile distilled water | Make up to 1 L |
Adjust the pH to 7.4 with 1N NaOH or 1N HCl.
Laboratory supplies
1. Culture bottles (Tarsons, catalog number: 20080)
2. Pots (Garden Aids, India, catalog number: AP-3)
3. Micropipettes (Eppendorf Research Plus, catalog number: 35016146026)
4. Petri dishes, 90 mm (Abdos, catalog number: 3165077)
5. 2 mL Eppendorf tubes (Abdos, catalog number: P10203)
6. 50 mL centrifuge tubes (Falcon, catalog number: 546024)
7. Filter paper (Sigma, catalog number: FP/310/AC)
8. Forceps (HiMedia, catalog number: LA821)
9. Cotton (HiMedia, catalog number: LA1018)
10. Parafilm (Tarsons, catalog number: 380020)
11. Red soil (PKM Nursery, Thiruvarur, Tamil Nadu)
12. Soilrite (Keltech Energies Limited, HSN code: 68062000)
13. Perlite (Keltech Energies Limited, HSN code: 27030090)
Equipment
1. Weighing balance (Shimadzu, model: ATX224)
2. Autoclave (Equitron, model: PAD NC01HF28837)
3. Centrifuge (Thermo Fisher, model: SORVALST16R)
4. Orbital shaker (C-Being Scientific Inc. model: BSI-3C)
5. Laminar air flow (Lab field, model: LFAS-110)
6. Plant growth chamber (SRL, model: PGC- 11)
7. UV spectrophotometer (Shimadzu, model: UV-1800)
Software and datasets
1. UV probe 2.0
Procedure
Notes:
1. The whole sterilization process should be done in a laminar air flow chamber.
2. Use autoclaved 50 mL centrifuge tubes (Falcon tubes).
A. Seed sterilization
1. Pre-soak rice and tomato seeds in water for 3 h.
2. Transfer 150 rice seeds (Aiswarya) into a 50 mL centrifuge tube and tomato PKM-1 seeds to a 2 mL Eppendorf tube. Add 8 mL of 70% ethanol to Aiswarya seeds and 2 mL of 70% ethanol to tomato seeds.
3. Incubate the seeds for 2 min at room temperature.
4. Discard ethanol and rinse twice with sterile distilled water.
5. Add 8 mL of 4% sodium hypochlorite to rice seeds and 2 mL to tomato seeds.
6. Incubate for 3 min at room temperature with gentle shaking.
7. Discard sodium hypochlorite and rinse the seeds vigorously with sterile water five times.
8. Air dry the sterilized seeds on sterile filter paper for 15–20 min.
Note: The entire sterilization process should be done in a laminar air flow chamber.
B. Bacterial culture
1. Primary culture
a. Add a single colony from a freshly prepared LB agar plate to 15 mL of LB broth.
b. Incubate it overnight at 30 °C and 180 rpm in an orbital shaker.
2. Secondary culture
a. Add 200 μL of the primary culture to 40 mL of LB broth.
b. Incubate it at 30 °C and 180 rpm in an orbital shaker until OD600 reaches 0.8.
3. Processing of bacterial culture
a. Centrifuge the bacterial culture at 3,522× g for 5 min to pellet down the bacterial cells.
b. Discard the media components (supernatant) and dissolve the pellet in 10 mL of 1× PBS.
c. Centrifuge the resuspended pellet at 3,522× g for 5 min.
d. Wash the pellet thrice by resuspending it in 1× PBS followed by centrifugation at 3,522× g for 5 min.
e. Resuspend the pellet either in 1× PBS or in sterile distilled water.
Note: Gently dissolve the pellet, do not shake vigorously.
C. Seed treatment with the bacterial inoculum and different growth conditions
1. Seed treatment with bacteria
a. Transfer sterilized seeds from section A to pellets resuspended in 1× PBS or water from section B using sterile forceps.
b. Transfer sterilized seeds from section A to 1× PBS or water (uninoculated control).
c. Incubate overnight in an orbital shaker at 30 °C and 180 rpm.
Note: After incubation, transfer seeds to sterile culture bottles for germination or directly to pots with sterile soil.
2. Different developmental stages
a. Early developmental stage (tissue culture bottles):
i. Place a thin layer of absorbent cotton in a sterile culture bottle and autoclave it at 121 °C (15 psi) for 20 min.
ii. Open the culture bottle inside the laminar hood and add 3 mL of autoclaved distilled water.
iii. Transfer ten seeds to the respective bottles, close them, and seal them with parafilm.
iv. Keep the bottles in the dark for 3 days for germination.
v. After germination, transfer the culture bottles to a growth chamber with 8/16 h light/dark photoperiod with 140 μmol·m-2·s-1 light intensity for 10 days.
b. Late developmental stage (pot study):
i. Wash the pots (200 mL capacity) and label them with the respective treatments.
ii. Take red soil, soilrite, and perlite in a 3:1:1 ratio and autoclave.
iii. Fill three-fourths of the 200 mL pots with sterile soil (150 g) and drench it with water.
Note: Treated seeds can be transferred directly to the pots or germinated in Petri plates for three days in the dark and then transferred to soil.
iv. Place treated seeds in the pots and cover them with a thin layer of sterile soil mix.
v. Place pots in a growth chamber with 8/16 h light/dark photoperiod with 140 μmol·m-2·s-1 light intensity at 22 °C.
3. Soil drenching with culture
a. Plants are ready for culturing ten days after germination.
b. After the secondary culture reaches 0.8 OD600, centrifuge the bacterial cells at 3,522× g for 5 min and discard the supernatant.
c. Wash the pellet thrice with 1× PBS and resuspend the cells in water.
d. Add 5 mL of pellet-resuspended water to each pot with bacterial treatment on days 11, 13, and 15 after germination.
e. Subsequent bacterial inoculation to plants is done every 15 days.
f. Add 5 mL of water to control plants.
Data analysis
PGPR inoculation on seeds and seedlings of plants was performed as shown in the Graphical overview. Uninoculated and PGPR-inoculated plants were taken out of culture bottles after 10 days of germination, and the root and shoot lengths were measured. Changes in root and shoot growth were monitored during late developmental stages from soil-grown plants.
Validation of protocol
Validation of this protocol is done by analyzing changes in the growth of monocot (Oryza sativa) and dicot (Lycopersicon esculentum) plants. Compared to uninoculated plants, improved root growth and shoot length were observed in inoculated plants in both early (10-day-old seedlings) and late developmental stages (2-month-old plants) (Figure 1) [12].

Acknowledgments
The authors acknowledge the SERB, India funded project (EEQ/2021/000498) to DC, Department of Biotechnology and Department of Microbiology, Central University of Tamil Nadu for common facilities.
Competing interests
The authors declare that they have no known competing financial interests or personal relationships that could have appeared to influence the work reported in this paper.
Ethical considerations
The information and work involved in this paper is submitted with ethical standards.
References
Article Information
Publication history
Received: Oct 16, 2024
Accepted: Feb 4, 2025
Available online: Feb 26, 2025
Published: Mar 20, 2025
Copyright
© 2025 The Author(s); This is an open access article under the CC BY-NC license (https://creativecommons.org/licenses/by-nc/4.0/).
How to cite
Somna, G., Sangwan, S., Baskar, C., Bakka, K. and Challabathula, D. (2025). Protocol for Inoculation of PGPR Staphylococcus sciuri to Seeds and Seedlings of Rice and Tomato Plants for Increased Root and Shoot Growth. Bio-protocol 15(6): e5241. DOI: 10.21769/BioProtoc.5241.
Category
Plant Science > Plant physiology > Plant growth
Biological Sciences > Biological techniques > Microbiology techniques
Plant Science > Plant immunity > Host-microbe interactions
Do you have any questions about this protocol?
Post your question to gather feedback from the community. We will also invite the authors of this article to respond.
Tips for asking effective questions
+ Description
Write a detailed description. Include all information that will help others answer your question including experimental processes, conditions, and relevant images.
Share
Bluesky
X
Copy link
